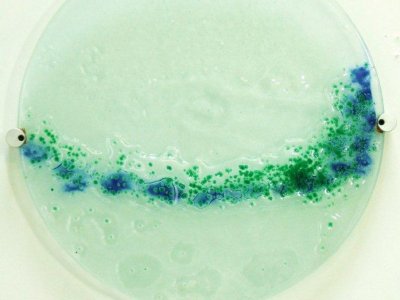
A Retrospective - Tim Long

Artizan / Events / Tue 14 to Sat 25 Feb 2017 (2 weeks)
A Retrospective - Tim Long
Final few days of this months exhibition, which is supported in the rear gallery by emerging photographer, Millie Fraser.
Torquay born Tim initially qualified in illustration and graphic design before his career path moved into Media Studies which he lectured on at an international level.
On his retirement from lecturing, Tim developed a fascination with the qualities of fused glass, and he began an exploration of the technique, experimenting with the quality of light and colour achievable through the form. Though initially he worked solely in float glass – a method creating sheet glass of uniform thickness – he soon expanded into a more colourful and challenging art form which could better express his life’s experiences.
His love of photography has left us with a fine record of his travels, his observations of people and life’s situations, but it is his work which offers the greatest insight into the man himself. Artizan is lucky to hold a small collection of his work which is on display in this exhibition, alongside additional contributions from his wife Helen Ridehalgh, a South West Academy sculptor who continues to work from their shared studio in Torquay.
For more information visit http://www.artizangallery.co.uk/article/382-tim-long
Event Location
Artizan Gallery
7 Lucius Street
Torquay
TQ2 5UW
Telephone: 01803 428 626
Email: juliebrandon@artizangallery.co.uk
Website: http://www.artizangallery.co.uk/article/382-tim-long
